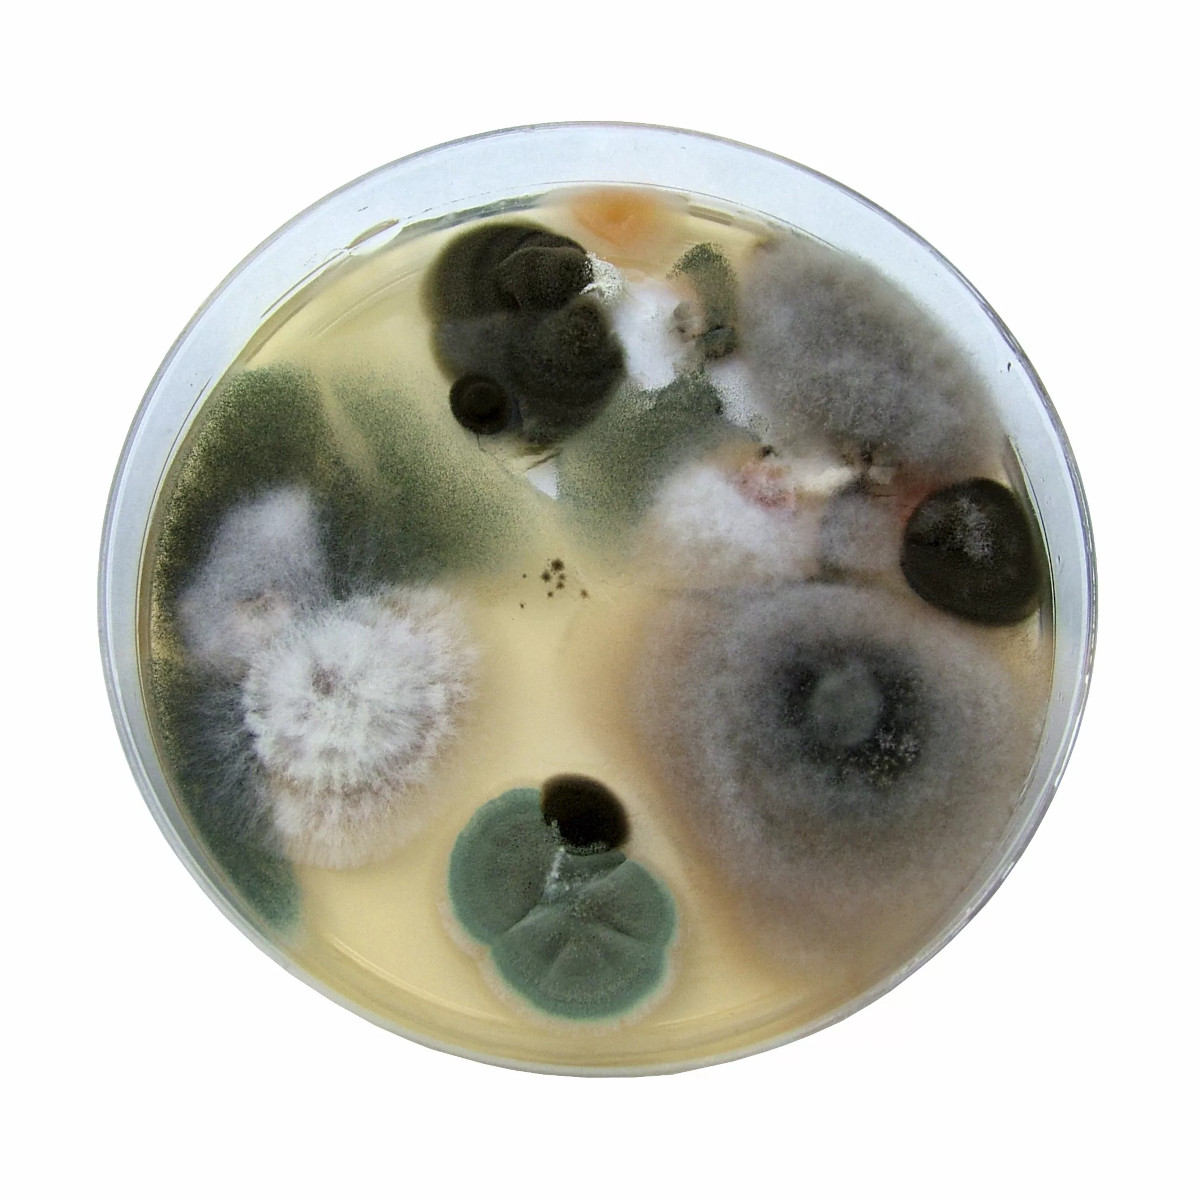

Полностью уничтожим все микроорганизмы
Плесень и способы ее удаления
Плесень это грибок, распространяющийся в темных влажных помещениях, практически на любых материалах. Причин появления плесени, огромное количество; основная из которых является; повышенная влажность: чаще всего появляется в помещениях с плохой системой вентиляции. Обнаружить плесенные наросты непросто, плесень бывает различных видов и цветов. Первые признаки, что у вас завелась плесень, это возможно будет неприятный запах. После этого вам следует тщательно осмотреть углы и потолок помещения. Присмотревшись, вы обнаружите плесенные наросты.
Плесень может оказаться, как безопасной, так и угрожающей здоровью человека. Плесень выделяет токсичные Микотаксины, отрицательно влияющие на другие живые организмы. Поэтому необходимо серьезно подойти к вопросу по удалению плесени в случае ее обнаружения.
Подготовка перед удалением плесени
Первое с чего стоит начать, это максимально уменьшить влажность помещения, потому что плесень распространяется только в помещениях с повышенной влажностью. Непосредственно перед осуществлением затеи по устранению плесени необходимо, проветрить помещение, после чего тщательно просушить.
Если в стенах или потолке есть трещины нужно их замазать. Необходимо взять шпатель или металлическую щетку, потом соскоблить со стен видимые наросты плесени, стараться по максимуму удалить все образования. Рассмотрим 2 наиболее эффективных способа: народное средство и нанесение специальных средств.
· Первый способ: необходимо купить медный купорос и растворить его в воде, консистенция 1 кг на 10 литров воды. Далее взять обыкновенную кисточку или валик и тщательно нанести раствор на стены и потолок по всему периметру, после чего дать высохнуть и повторно нанести слой.
· Второй способ: в магазине купить противогрибковое средство, на ваше усмотрение, и с помощью пулевизатора нанести на всю обрабатываемую площадь несколько раз, давая каждому слою подсохнуть. После окончательного слоя, дать помещению высохнуть.
Обратитесь к профессионалам!
После того как помещение высохло, необходимо нанести 2 слоя грунтовки. Антисептическую и грунтовку глубокого проникновения. После этих процедур ваше помещение не будет подвержено атакам грибка. Также в случаях, большого распространения плесенного грибка лучше для вашей безопасности будет обратиться в специальные компании по устранению и дезинфекции помещений.